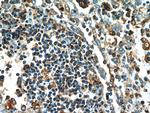
Caspase 1/p20/p10 Antibody in Immunohistochemistry (Paraffin) (IHC (P))

Search
Proteintech
Caspase 1/p20/p10 Polyclonal Antibody
{{$productOrderCtrl.translations['antibody.pdp.commerceCard.promotion.promotions']}}
{{$productOrderCtrl.translations['antibody.pdp.commerceCard.promotion.viewpromo']}}
{{$productOrderCtrl.translations['antibody.pdp.commerceCard.promotion.promocode']}}: {{promo.promoCode}} {{promo.promoTitle}} {{promo.promoDescription}}. {{$productOrderCtrl.translations['antibody.pdp.commerceCard.promotion.learnmore']}}
产品信息
22915-1-AP
种属反应
已发表种属
宿主/亚型
分类
类型
抗原
偶联物
形式
浓度
规格
纯化类型
保存液
内含物
保存条件
运输条件
产品详细信息
22915-1-AP can recognize all five isoforms of caspase 1. It also recognizes p45 procaspase and the mature fragments p10 and p20.
Immunogen sequence: MADKVLKEK RKLFIRSMGE APQAVQDNPA MPTSSGSEGN VKLCSLEEAQ RIWKQKSAEI YPIMDKSSRT RLALIICNEE FDSIPRRTGA EVDITGMTML LQNLGYSVDV KKNLTASDMT TELEAFAHRP EHKTSDSTFL VFMSHGIREG ICGKKHSEQV PDILQLNAIF NMLNTKNCPS LKDKPKVIII QACRGDSPGV VWFKDSVGVS GNLSLPTTEE FEDDAIKKAH IEKDFIAFCS STPDNVSWRH PTMGSVFIGR LIEHMQEYAC SCDVEEIFRK VRFSFEQPDG RAQMPTTERV TLTRCFYLFP GH (1-311 aa encoded by BC062327)
靶标信息
Caspases are a family of cysteine proteases that can be divided into the apoptotic and inflammatory caspase subfamilies. Unlike the apoptotic caspases, members of the inflammatory subfamily are generally not involved in cell death but are associated with the immune response to microbial pathogens. Members of this subfamily include caspase-1, -4, -5, and -12 and can activate proinflammatory cytokines such as IL-1-b and IL-18. Caspase-1 was initially identified as an IL-1-b-converting enzyme; later experiments revealed it to be a mammalian homolog of the C. elegans cell death gene ced-3 whose overexpression can induce apoptosis in fibroblasts.
仅用于科研。不用于诊断过程。未经明确授权不得转售。
生物信息学
蛋白别名: CASP-1; caspase 1, apoptosis-related cysteine peptidase; Caspase-1; cysteine protease; ICE; IL-1 beta-converting enzyme; IL-1B converting enzyme; IL-1BC; IL1B-convertase; interleukin 1 beta-converting enzyme; interleukin 1, beta, convertase; interleukin 1-B converting enzyme; Interleukin 1beta converting enzyme; Interleukin-1 beta convertase; Interleukin-1 beta-converting enzyme; p45; unnamed protein product
基因别名: CASP1; ICE; IL1BC; IL1BCE; P45
UniProt ID: (Human) P29466, (Mouse) P29452
Entrez Gene ID: (Human) 834, (Mouse) 12362, (Rat) 25166